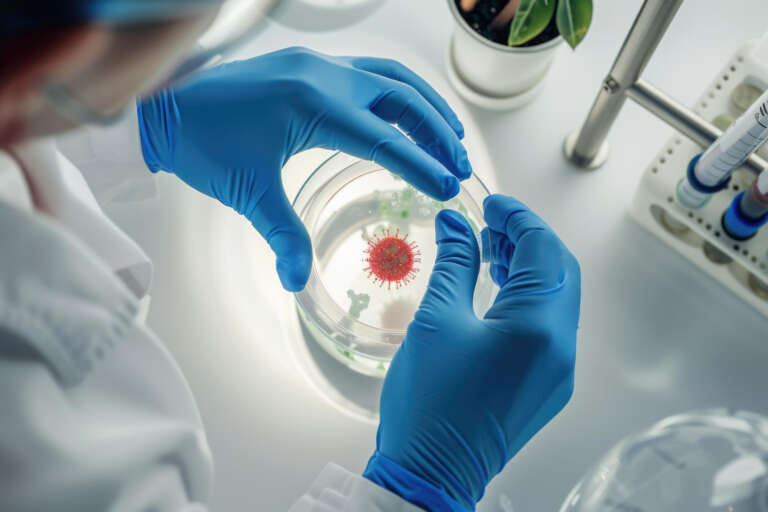
Pathogens

Food Testing Labs
- Home
- Food Testing Labs
Taste for the buds and trust for the heart!
In today’s market, delicious isn’t enough; your food must prove it’s safe, authentic, and compliant before it wins trust.
At Lab KinX, we believe that food safety is non-negotiable. Before reaching shelves or export markets, every product must first pass the test of quality, safety, and compliance. That’s where we step in, connecting you with the right accredited laboratories for every food testing requirement.
Through our network of accredited national and international partner labs, we ensure your products comply with FSSAI, US, FDA, EU standards, and other global regulations.
From nutritional analysis to Macronutrients checks and bio-fertiliser, we streamline the process so that manufacturers, exporters, and food businesses can focus on growth while we ensure compliance.

- Comprehensive testing for nutritional, microbiological, and chemical parameters.
- Compliance with FSSAI, EU, US FDA, and other domestic and global regulations.
- Fast and reliable results with transparent reporting.
Tests We Provide
We provide a varied range of tests to ensure efficacy & compliance.
Food Tests
Pathogens
Lab KinX’s pathogen testing identifies harmful microorganisms like Salmonella, E. coli, and Listeria. Using rapid and culture-based techniques, we detect contamination before it becomes a crisis. Food safety begins with foresight.

Six Monthly Compliance Testing (FSSAI)
Routine testing every six months keeps your compliance intact and your brand credible. Lab KinX simplifies recurring testing through subscription-based plans and reminders.

Allergen Test
Even a trace allergen can trigger reactions, our tests ensure your labels speak truth. We detect milk, soy, nuts, gluten, and other major allergens with ELISA precision.

Food Additives
Our additive testing screens for preservatives, colors, and flavor enhancers to verify permissible limits. Lab KinX helps brands maintain both compliance and quality.

Cholesterol
Through enzymatic and chromatographic methods, we quantify cholesterol with accuracy that supports health claims. It is ideal for dairy, meat, and processed foods.

Meat Specification
We verify species identity, composition, and quality parameters for meat and poultry. Lab KinX safeguards authenticity through DNA-based and chemical testing.

Fatty Acid Profile
Our detailed fatty acid profiling reveals the balance of saturated, unsaturated, and trans fats. Essential for nutritional labelling and R&D optimization.Science-backed insights for healthier formulations.

Sensory Evaluation
Lab KinX conducts expert sensory panels to assess taste, aroma, and texture. We translate human perception into measurable data.

Flavour Profiling
Our GC–MS flavour analysis decodes volatile compounds that shape your product’s aroma signature. We help R&D teams refine recipes for consistency and distinction.

Fortified Food
We validate vitamin and mineral fortification claims with precise quantification. From iron to folic acid, every nutrient is measured to the microgram.

Antibiotic Residue
Lab KinX screens food and feed for antibiotic residues that threaten public health. Our LC-MS/MS systems deliver reliable, regulatory-grade results.

Metal Contamination
Beyond heavy metals, we detect traces of nickel, tin, and other contaminants introduced during processing. Safeguard your manufacturing line and your reputation.

Heavy Metal Residue
We identify traces of lead, cadmium, arsenic, and mercury using highly sensitive instruments. Lab KinX ensures your products meet FSSAI and global standards for heavy metal limits.

Quality Standards
Lab KinX benchmarks your food products against national and international quality norms. We translate data into compliance, helping you meet specifications with confidence.

Health Supplement
We test nutraceuticals and supplements for purity, potency, and label accuracy. Lab KinX ensures your formulations deliver what they promise, no more, no less.

Toxins Test
Detect aflatoxins, mycotoxins, and other natural contaminants with our advanced testing suite. Lab KinX helps you stay compliant with export-grade limits. Because invisible toxins need visible vigilance.

Marine & Aquaculture
We test fish, shrimp, and marine products for heavy metals, antibiotics, and freshness indicators. Lab KinX helps exporters meet stringent international norms.

Oil Seeds Testing
From moisture to peroxide value, we analyze oil seeds for purity, yield, and safety. Our testing ensures consistency in edible oil production.

Vitamins & Minerals
Lab KinX quantifies vitamins, minerals, and trace elements with precision for fortified and functional foods. Our methods meet Codex and FSSAI standards.

Preservatives
Our preservative testing ensures that shelf-life extenders stay within safe limits. Lab KinX evaluates sorbates, benzoates, and nitrates with regulatory precision.

Adulterants
We identify substitution, dilution, or mixing of inferior ingredients through advanced detection techniques. From milk to spices, every deception has a chemical signature, and we catch it.

Antioxidants
Measure the total antioxidant capacity and individual antioxidant compounds with advanced assays. Lab KinX helps you substantiate functional food claims with data that speaks.

Crop Contamination
Our soil-to-silo testing identifies chemical, biological, and environmental contaminants in crops. Lab KinX ensures agricultural produce meets global food safety benchmarks.

Drug Residue
Ensure your animal-based products are free from veterinary drug residues and pesticides. Lab KinX’s precise residue testing keeps exports compliant and consumers safe

FASSI, EU & Other Country Specific Tests
Global markets demand precision, and Lab KinX delivers it. Our country-specific testing protocols align with EU, US FDA, and other international regulatory frameworks, ensuring your exports meet every regional requirement.

GMO Testing
Detect and quantify genetically modified ingredients with validated molecular methods. Lab KinX ensures your products meet global GMO regulations with trace-level accuracy.

ETO Testing
Ethylene oxide residues can compromise safety we make sure they don’t. Our ETO analysis precisely measures residual gases used in sterilization. Stay compliant and safeguard consumer health, every batch, every time.

Food Contaminants
Every stage of food production carries the risk of unwanted intruders, from chemical residues to biological threats. Lab KinX identifies and quantifies contaminants that compromise quality, safety, and compliance.

Microbiology Testing
We assess total bacterial counts, yeast, and molds to ensure microbial safety. From raw ingredients to finished goods, every sample is meticulously screened. A hygienic supply chain begins with science.

Shelf Life Studies
We simulate real-time and accelerated conditions to determine how long your product stays safe and effective. Our shelf life studies track sensory, chemical, and microbial changes across time.

FSSAI Compliance
Lab KinX ensures your products meet every benchmark set by the Food Safety and Standards Authority of India (FSSAI). From ingredient validation to labelling accuracy, we help you navigate complex regulations with absolute clarity.

Nutritional Labelling
Lab KinX provides precise nutritional analysis for packaged foods to ensure regulatory compliance and transparency. Our reports outline macro and micronutrients with unmatched accuracy.

Other Testing
We provide customized testing for foods requiring specialized analysis, covering advanced chemical, microbial, and regulatory parameters with precise reporting.
Fertiliser Tests

OTHERS
Includes specialty and organic fertilisers tested for nutrient balance, heavy metals, and organic matter content. Ensures sustainable and safe agricultural application.

POTASSIC FERTILISERS
Determines potassium concentration and chemical form. Tests solubility and purity for efficient nutrient release.

PHOSPHATIC FERTILISERS
Analyses available and total phosphorus content. Evaluates solubility, reactivity, and compliance with agronomic standards.

NITROGENOUS FERTILISERS
Assesses nitrogen content, form (ammoniacal, nitrate, urea), and release efficiency. Detects contaminants and verifies labeling claims.

MACRONUTRIENTS
Quantifies nitrogen, phosphorus, and potassium levels. Assesses nutrient availability and physical properties affecting plant uptake.

MICRONUTRIENTS
Determines trace elements like zinc, iron, manganese, and boron. Ensures correct concentration, solubility, and absence of toxic impurities.

FORTIFIED FERTILISERS
Checks fortification accuracy with micronutrients or bio-stimulants. Ensures stability, homogeneity, and compliance with enrichment standards.

FERTILISER MIXTURES
Analyses nutrient composition and uniformity of blended formulations. Confirms declared NPK ratios and detects impurities.

BIO-FERTILISER
Evaluates microbial viability, strain purity, and carrier quality. Ensures efficacy in nitrogen fixation or phosphate solubilisation.

FERTILISER MIXTURES
Analyses nutrient composition and uniformity of blended formulations. Confirms declared NPK ratios and detects impurities
- General Test
- Dairy Products and Analogues
- Fats, Oils and Fat Emulsions
- Cereals and Cereal Products
- Meat and Meat Products
- Fish and Fish Products
- Fruit & Vegetable Products
- Sweets & Confectionery
- Sweetening Agents Including Honey
- Salt, Spices, Condiments and Related Products
- Beverages, (other Than Dairy and Fruits & Vegetables Based)
- Other Food Product and Ingredients
- Proprietary Food
- Radiation Processing of Food
- Gluten-Free Food
- Hemp Seed & Seed Products
- Food Additives
- Fertiliser
- Fertiliser Mixtures
- Fortified Fertilisers
- Macronutrients
- Nitrogenous Fertilisers
- Phosphatic Fertilisers
- Potassic Fertilisers
- Others
Testing Scope
- Packaged foods and beverages
- Raw ingredients and processed products.
- Export consignments requiring certification.
Industries We Serve
Baby Food Testing
Dry Fruit Testing
Chocolate Testing
Pet Food Testing
Processed Food Testing
Fruit & Vegitable Products
Cereals & Cereal Products
Sweets & Confectionery
Sweetening Agents Including Honey
Seafood Testing
Food Packaging & Migration
Grains Testing
Herbal Products Testing
Honey Testing
Egg & Egg Products
Juices & Pulp
Meat Products Testing
Milk and Dairy Products Testing
Nutraceuticals
Oils & Fats
Spices
Tea Testing
Tobacco Testing
Proprietery Food
Water Testing
Fortified Foods
Prebiotics and Probiotics
- Baby Food Testing
- Chocolate Testing
- Dry Fruits Testing
- Egg & Egg Products Testing
- Food Packaging & Migration
- Seafood Testing
- Tobacco Testing
- Prebiotics and Probiotics
- Grains Testing
- Herbal Products Testing
- Honey Testing
- Juices & Pulp
- Meat Products Testing
- Spices
- Total Polar Compounds in Edible Oils
- Milk and Dairy Products Testing
- Nutraceuticals
- Oils & Fats
- Pet Food Testing
- Processed Food Testing
- Tea Testing
- Fortified Foods
- Water Testing
